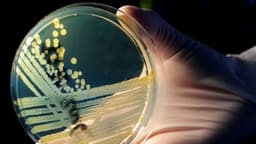
Investigador chino acusado de contrabandear peligrosa bacteria a Estados Unidos

Un antiguo investigador chino de biología de la Universidad de Indiana en Bloomington fue sentenciado por introducir de contrabando muestras de ADN de la bacteria E. coli en Estados Unidos desde China, según anunció el 10 de abril la Fiscalía del Distrito Sur de Indiana.
Youhuang Xiang, de 32 años, quien se encontraba en Estados Unidos con una visa de no inmigrante J-1 procedente de China, fue imputado formalmente en diciembre de 2025. El 7 de abril, fue sentenciado a la pena impuesta, o más de cuatro meses, una multa de 500 dólares y un año de libertad condicional supervisada, tras declararse culpable de un cargo de contrabando y aceptar una orden judicial de deportación a China.
Durante la audiencia de sentencia celebrada el 7 de abril en la corte federal de distrito de Indianápolis, los fiscales presentaron pruebas de que Xiang era miembro del Partido Comunista Chino (PCCh) y que mintió sobre su afiliación al PCCh cuando fue interrogado por funcionarios de inmigración.
"Este miembro del Partido Comunista Chino se aprovechó de una subvención federal para investigación del USDA [Departamento de Agricultura de los Estados Unidos] para introducir de contrabando material biológico peligroso en los Estados Unidos. El remitente mintió en el manifiesto para ocultar la naturaleza peligrosa del envío", declaró el inspector general del USDA, John Walk, en un comunicado.
"Seguiremos trabajando codo con codo con nuestros socios encargados de hacer cumplir la ley, como la CBP y el FBI, para combatir el fraude comercial y detener la explotación por parte de adversarios extranjeros de las subvenciones federales administradas por el USDA".
Según la fiscalía estadounidense, Xiang, doctor por la Academia China de Ciencias, organismo estatal, obtuvo el visado para realizar una investigación postdoctoral en la universidad a partir del 12 de junio de 2023.
En noviembre de 2025, la oficina del FBI en Indianápolis inició una investigación sobre envíos sospechosos procedentes de China dirigidos a personas vinculadas a la universidad, según consta en documentos judiciales. Posteriormente, agentes del FBI descubrieron que Xiang había recibido un envío sospechoso de China en su domicilio en Bloomington, Indiana, en marzo de 2024.
Según los fiscales, el envío procedía de una empresa con sede en China llamada Guangzhou Sci‑Tech Innovation Trading y fue declarado como "ropa interior de fibras sintéticas, otras prendas femeninas".
"El FBI consideró extraño que Xiang comprara y enviara ropa interior femenina desde China, y además le pareció peculiar que una empresa llamada 'Guangzhou Sci Tech Innovation Trading' vendiera ropa interior o prendas de vestir", escribió un agente del FBI en una declaración jurada presentada junto con la denuncia penal.
Según la fiscalía, el 23 de noviembre de 2025, Xiang fue interrogado por agentes de Aduanas y Protección Fronteriza en el Aeropuerto Internacional O'Hare de Chicago a su regreso a Estados Unidos tras un viaje de investigación al Reino Unido. Durante el interrogatorio, Xiang afirmó inicialmente desconocer cualquier actividad de contrabando, pero posteriormente admitió que el envío que recibió había sido etiquetado erróneamente de forma intencionada para ocultar las muestras de ADN de E. coli.
"Xiang reconoció además que sabía que se requería un permiso para enviar material biológico a Estados Unidos y que, a sabiendas, no lo obtuvo. Xiang también admitió que él, y quienes le enviaban la bacteria E. coli desde China, intentaron ocultar las muestras de E. coli en el envío de ropa para eludir la ley estadounidense", reza la declaración jurada del FBI.
Según la fiscalía estadounidense, el Servicio de Aduanas y Protección Fronteriza de Estados Unidos posteriormente canceló la visa de Xiang, y este fue arrestado por el FBI.
La E. coli, abreviatura de Escherichia coli, se considera un organismo modelo para los investigadores debido a su rápido crecimiento y su facilidad de manipulación genética, según la Sociedad Estadounidense de Microbiología. Los científicos utilizan la E. coli para estudiar la regulación génica, las mutaciones genéticas y la ingeniería genética.
"Xiang aprovechó intencionadamente su acceso a las instalaciones de laboratorio de una de las universidades de investigación más importantes de Indiana, así como los privilegios de su visado J-1, para introducir ilegalmente material biológico en Estados Unidos", declaró Tom Wheeler, fiscal federal del Distrito Sur de Indiana, en un comunicado.
"Conductas como la de Xiang eluden la inspección diligente de sustancias potencialmente dañinas por parte de la CBP, el USDA y aquellos organismos que, por ley, deben prevenir la introducción de materiales biológicos invasivos y dañinos en nuestro país".
El memorándum de sentencia del acusado incluía varias cartas presentadas ante la corte en defensa de las acciones y el carácter de Xiang, incluida una de Armin Moczek, director del Departamento de Biología de la universidad.
"Quisiera recalcar que el uso de ADN plasmídico —el tipo de ADN del que se acusa al Dr. Xiang de haber introducido de contrabando en el país— es una práctica habitual entre los biólogos moleculares, tan habitual de hecho que se la enseñamos a estudiantes de primer año de pregrado y a becarios de secundaria", escribió Moczek en una carta fechada el 23 de marzo.
El periódico The Epoch Times no pudo ponerse en contacto con los representantes legales de Xiang para solicitar comentarios.